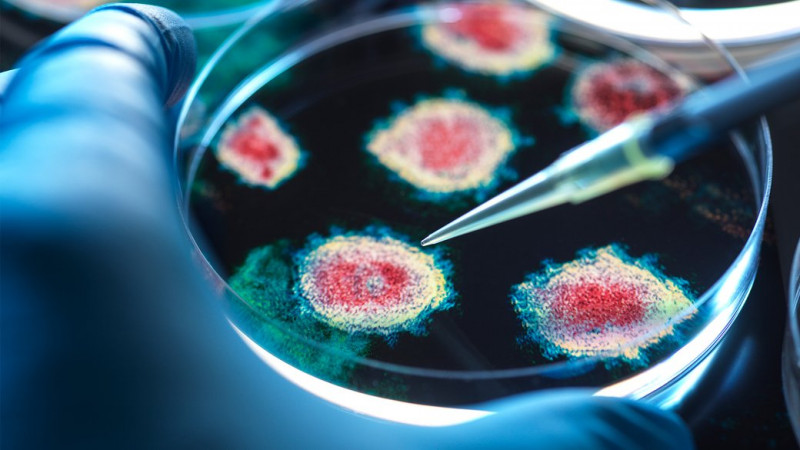

За інформацією: Суспільне Чернігів.
Віруси. Getty Іmages
У січні 2026 року в закладах охорони здоров'я Чернігова зафіксували 52 випадки захворювання на грип А. За аналогічний період минулого року таких випадків було 11.
Про це Суспільному повідомив заступник генерального директора Чернігівського обласного центру контролю та профілактики хвороб Артем Ярошенко.
"По області ми моніторимо загальну захворюваність на ГРВІ, ми не можемо виділити окремо кількість хворих на грип. По грипу ми моніторимо лише дозорні заклади Чернігова, відповідно до наказу МОЗ. Дозорні заклади — це дитячий і дорослий станціонари, поліклініка доросла і дитяча. За перший тиждень січня ми зафіксували 11 випадків грипу А, за другий — 12, за третій — 15, за четвертий — 14".

Артем Ярошенко. Суспільне Чернігів (архів)
З 52-х випадків грипу А, зафіксували 19 випадків підтипу вірусу грипу А — H3N2. Він поширюється швидко і викликає ускладнення, особливо у людей старшого віку та тих, хто має хронічні захворювання.
"Грип А небезпечний своїми наслідками. При невчасному зверненні за медичною допомогою, при невідповідному лікуванню, він викливає пневмонію і далі різні ускладнення. Якщо людина має якісь хронічні захворювання, то цей грип призводить до ускладнень легень, сечовидільної системи і хвороби кровотворення".
Щоб уберегтися Артем Ярошенко радить:
"Перше — треба вакцинуватися. Потрібно уникати переохолодження, масових скупчень людей, собливо, коли ви бачите, що хтось має ознаки грипу чи ГРВІ. Треба тепло одягатися, ноги берегти. Потрібно приймати вітаміни, не займатися самолікуванням, а звертатися до лікарні".
